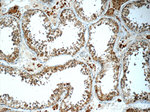
TSP50 Antibody in Immunohistochemistry (Paraffin) (IHC (P))

Search
Proteintech
TSP50 Polyclonal Antibody
{{$productOrderCtrl.translations['antibody.pdp.commerceCard.promotion.promotions']}}
{{$productOrderCtrl.translations['antibody.pdp.commerceCard.promotion.viewpromo']}}
{{$productOrderCtrl.translations['antibody.pdp.commerceCard.promotion.promocode']}}: {{promo.promoCode}} {{promo.promoTitle}} {{promo.promoDescription}}. {{$productOrderCtrl.translations['antibody.pdp.commerceCard.promotion.learnmore']}}
产品信息
12574-1-AP
种属反应
已发表种属
宿主/亚型
分类
类型
抗原
偶联物
形式
浓度
规格
纯化类型
保存液
内含物
保存条件
运输条件
产品详细信息
Immunogen sequence: LRSAGCWGA GEAPGALSTA DPADQSVQCV PKATCPSSRP RLLWQTPTTQ TLPSTTMETQ FPVSEGKVDP YRSCGFSYEQ DPTLRDPEAV ARRWPWMVSV RANGTHICAG TIIASQWVLT VAHCLIWRDV IYSVRVGSPW IDQMTQTASD VPVLQVIMHS RYRAQRFWSW VGQANDIGLL KLKQELKYSN YVRPICLPGT DYVLKDHSRC TVTGWGLSKA DGMWPQFRTI QEKEVIILNN KECDNFYHNF TKIPTLVQII KSQMMCAEDT HREKFCYELT GEPLVCSMEG TWYLVGLVSW GAGCQKSEAP PIYLQVSSYQ HWIWDCLNGQ ALALPAPSRT LLLALPLPLS LLAAL (32-385 aa encoded by B C033016)
靶标信息
Testes-specific protease 50 (TSP50) is a gene located within the chromosome region 3p21.31, primarily expressed in testicular tissue, and is homologous to serine proteases. However, TSP50 contains a distinctive catalytic triad where serine, a crucial catalytic residue, is replaced by threonine, allowing it to exhibit a novel protease activity. TSP50 is recognized for its role as a pro-oncogene, contributing significantly to cancer progression by promoting aerobic glycolysis, known as the Warburg effect, in hepatocellular carcinoma cells through interaction with pyruvate kinase M2 isoform (PKM2). This function underlines its involvement in cancer metabolism, as it attenuates colitis by regulating TGF-β signaling pathways. Furthermore, studies have linked TSP50 to cancer stem cell maintenance, driving stem-like properties in breast cancer cells, thereby facilitating tumor initiation and self-renewal capabilities. These characteristics highlight TSP50's potential as a target in therapeutic interventions for cancer treatment.
仅用于科研。不用于诊断过程。未经明确授权不得转售。
生物信息学
蛋白别名: Cancer/testis antigen 20; Probable threonine protease PRSS50; protease, serine 50; protease, serine, 50; Serine protease 50; testes-specific protease 50; testicular tissue protein Li 210; Testis-specific protease-like protein 50
基因别名: 79H19C; CT20; PRSS50; TSP50
UniProt ID: (Human) Q9UI38, (Mouse) Q8BLH5
Entrez Gene ID: (Human) 29122, (Mouse) 235631